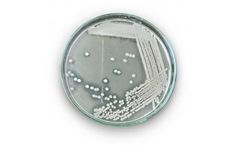
JBMbio - Model 0130.1 - Bacillus Coagulans

- Home
- Equipment
Refine by
Jbmbio Agricultural Equipment & Supplies
3 equipment items found
Manufactured by:JBMbio.com based inArmada, MICHIGAN (USA)
EnviroDEFENSE Enhanced Plant Growth (EPG™) is a probiotic for all green leafed plants with Plant Growth Promoting Rhizobacteria (PGPR). EPG is not a fertilizer - it just makes fertilizer more effective, delivering fertilizers and minerals to the plant, retaining more in the soil, and increasing nutrient uptake. EPG improves growth, vigor and tolerance to stress. Less fertilizer is lost as ...
Manufactured by:JBMbio.com based inArmada, MICHIGAN (USA)
Bacillus coagulans is a type of good bacteria, also known as a probiotic. It produces lactic acid, but isn’t the same thing as Lactobacillus. Bacillus coagulans. The big advantage to a Bacillus coagulans is its ability to generate spores during its reproductive life cycle. This ability allows Bacillus coagulans to go dormant and survive harsh environmental conditions, which might kill off ...
Manufactured by:JBMbio.com based inArmada, MICHIGAN (USA)
Traditional animal feed ingredients are primarily produced from corn, cereals, and wheat, and although those components provide much-needed nutrients for the animal, they are difficult to completely digest. If ignored, undigested food can cause weight loss, diarrhea, decreased production of bile, over-production of stomach acid and even ...